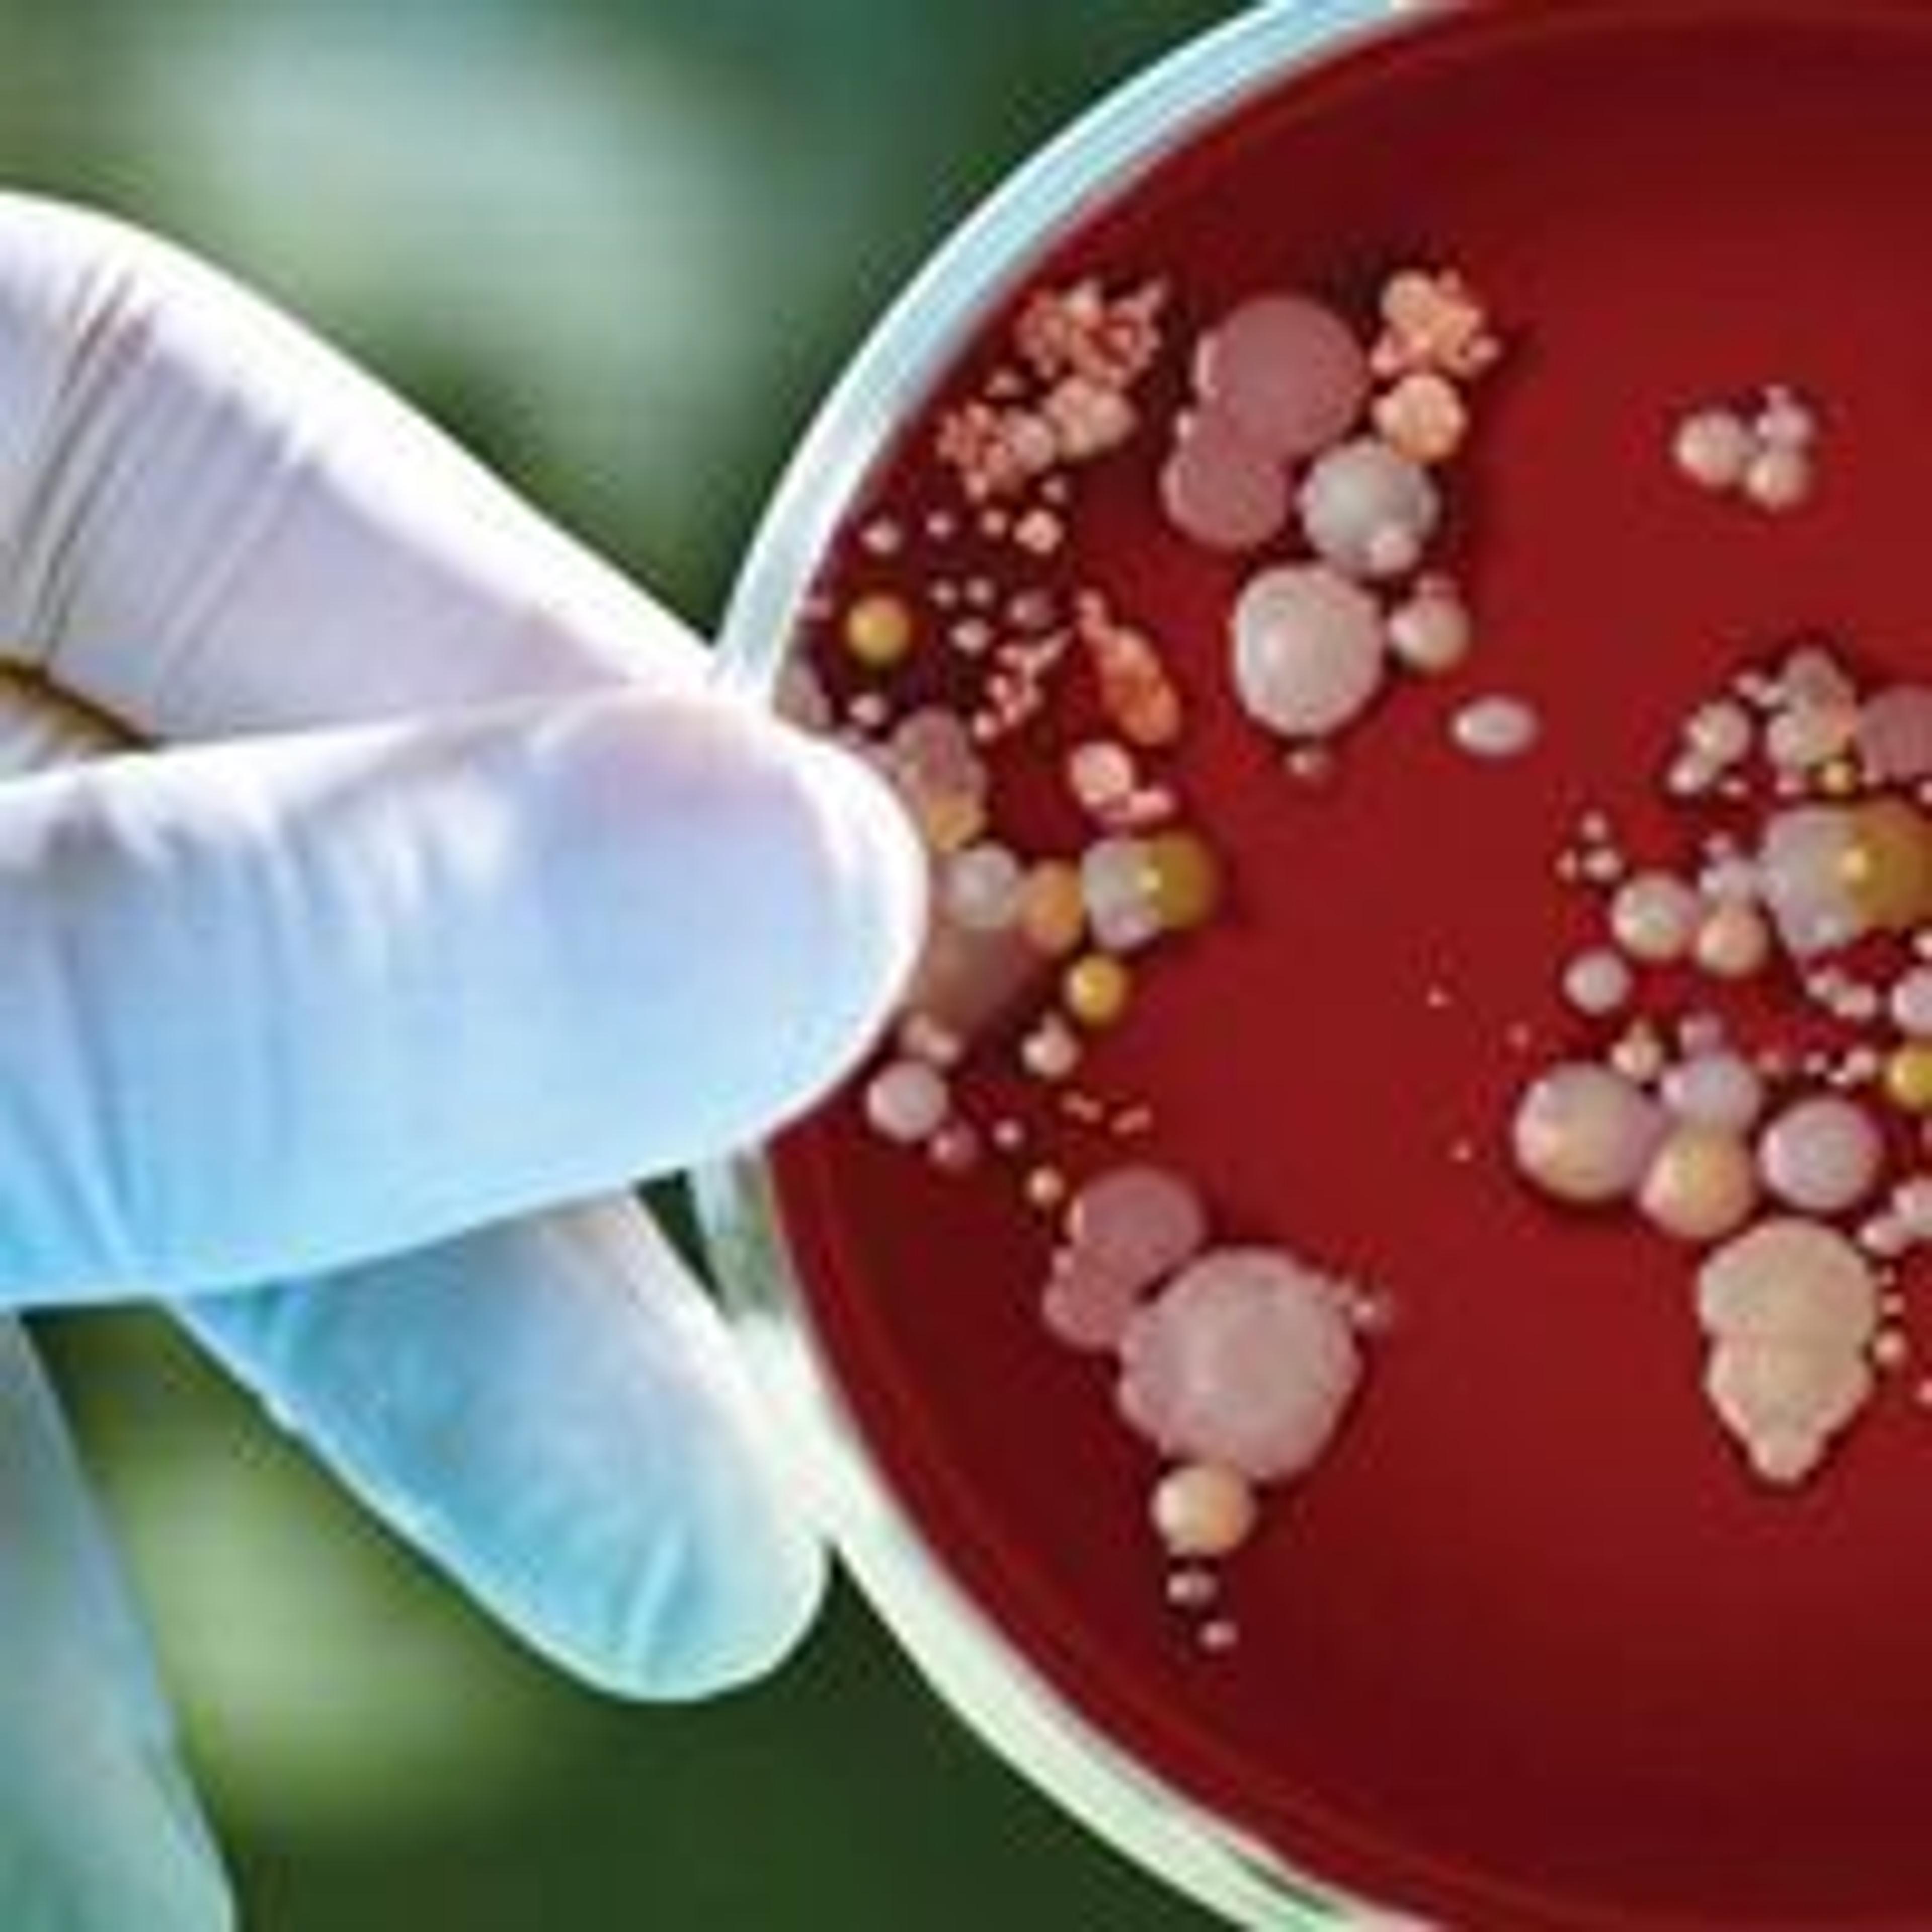

News & Articles
25
Industry News
Almac Receives FDA Inspection Approval
Industry News
ELRIG Launch Drug Discovery ’13
Industry News
HORIBA Medical UK Incorporated into HORIBA UK Ltd
Industry News
INTEGRA Biosciences Announces French Subsidiary
Industry News